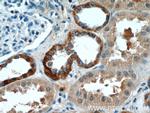
SIL1 Antibody in Immunohistochemistry (Paraffin) (IHC (P))

Search
Proteintech
SIL1 Polyclonal Antibody
{{$productOrderCtrl.translations['antibody.pdp.commerceCard.promotion.promotions']}}
{{$productOrderCtrl.translations['antibody.pdp.commerceCard.promotion.viewpromo']}}
{{$productOrderCtrl.translations['antibody.pdp.commerceCard.promotion.promocode']}}: {{promo.promoCode}} {{promo.promoTitle}} {{promo.promoDescription}}. {{$productOrderCtrl.translations['antibody.pdp.commerceCard.promotion.learnmore']}}
产品信息
24110-1-AP
种属反应
已发表种属
宿主/亚型
分类
类型
抗原
偶联物
形式
浓度
规格
纯化类型
保存液
内含物
保存条件
运输条件
产品详细信息
Immunogen sequence: GSHVRLNLQ TGEREAKLQY EDKFRNNLKG KRLDINTNTY TSQDLKSALA KFKEGAEMES SKEDKARQAE VKRLFRPIEE LKKDFDELNV VIETDMQIMV RLINKFNSSS SSLEEKIAAL FDLEYYVHQM DNAQDLLSFG GLQVVINGLN STEPLVKEYA AFVLGAAFSS NPKVQVEAIE GGALQKLLVI LATEQPLTAK KKVLFALCSL LRHFPYAQRQ FLKLGGLQVL RTLVQEKGTE VLAVRVVTLL YDLVTEKMFA EEEAELTQEM SPEKLQQYRQ VHLLPGLWEQ GWCEITAHLL ALPEHDAREK VLQTLGVLLT TCRDRYRQDP QLGRTLASLQ AEYQVLASLE LQDGEDEGYF QELLGSVNSL LKELR (88-461 aa encoded by B C011568)
靶标信息
This gene encodes a resident endoplasmic reticulum (ER), N-linked glycoprotein with an N-terminal ER targeting sequence, 2 putative N-glycosylation sites, and a C-terminal ER retention signal. This protein functions as a nucleotide exchange factor for another unfolded protein response protein. Mutations in this gene have been associated with Marinesco-Sjogren syndrome. Alternate transcriptional splice variants have been characterized.
仅用于科研。不用于诊断过程。未经明确授权不得转售。
生物信息学
蛋白别名: BAP; BiP-associated protein; endoplasmic reticulum localized nucleotide exchange factor for BiP; homolog of yeast; Nucleotide exchange factor SIL1; SIL1 homolog endoplasmic reticulum chaperone (S. cerevisiae) isoform SIL1_1; SIL1 homolog endoplasmic reticulum chaperone (S. cerevisiae) isoform SIL1_2; SIL1 homolog, endoplasmic reticulum chaperone; SIL1 protein; SIL1-like protein endoplasmic reticulum chaperone; unnamed protein product
基因别名: 1810057E01Rik; AI042831; BAP; MSS; SIL1; ULG5; UNQ545/PRO836; wz
UniProt ID: (Human) Q9H173, (Rat) Q6P6S4, (Mouse) Q9EPK6
Entrez Gene ID: (Human) 64374, (Rat) 291673, (Mouse) 81500